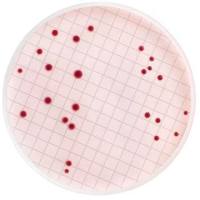
MB000000E Merck 默克	m-Endo总大肠菌群肉汤（脱水）

相关产品推荐更多 >
万千商家帮你免费找货
0 人在求购买到急需产品
- 详细信息
- 文献和实验
- 技术资料
- 库存:
999
- 保修期:
可咨询
- 现货状态:
可咨询
- 供应商:
默克
- 规格:
90210-250G
一般描述
应用

风险提示:丁香通仅作为第三方平台,为商家信息发布提供平台空间。用户咨询产品时请注意保护个人信息及财产安全,合理判断,谨慎选购商品,商家和用户对交易行为负责。对于医疗器械类产品,请先查证核实企业经营资质和医疗器械产品注册证情况。
文献和实验Analysis of Proteins using Small Format 2D Gel Electrophoresis
twice with PBS-A and lysed in 0.2 ml of 2D lysis buffer (0.01M Tris-HCl, pH 7.4, 1mM EDTA, 8M urea, 0.05M dithiothreitol, 10% (v/v) glycerol, 5% (v/v) Nonidet P-40, 200µg/ml RNAse A, 6% (w/v) pH 3.5-10 carrier ampholytes ("Resolyte", Merck
. and Becher, G. 2000. Synthesis, base pairing, and fluorescence properties of oligonucleotides containing 1H‐pyrazolo[3,4‐d]pyrimidin‐6‐amine (8‐aza‐7‐deazapurin‐2‐amine) as an analogue of purin‐2‐amine. Helv. Chim. Acta 83:928‐942
Analysis of Proteins using Small Format 2D Gel Electrophoresis
-A and lysed in 0.2 ml of 2D lysis buffer (0.01M Tris-HCl, pH 7.4, 1mM EDTA, 8M urea, 0.05M dithiothreitol, 10% (v/v) glycerol, 5% (v/v) Nonidet P-40, 200µg/ml RNAse A, 6% (w/v) pH 3.5-10 carrier ampholytes ("Resolyte", Merck Ltd.)) for 5 minutes on ice
技术资料暂无技术资料 索取技术资料